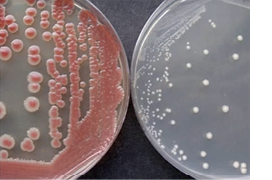

形态学检验技术在临床微生物鉴定中的应用价值

陈东科,三亚市人民医院丨四川大学华西三亚医院检验科指导专家。曾就职于北京医院检验科微生物实验室,从事临床微生物学检验工作三十余年,在感染性疾病病原学诊断、病原菌的分离与鉴定、病原微生物形态学、病原菌耐药监测、菌种保存、抗生素药效学研究方面有深入研究。发表论文90余篇,主编专著5部《实用临床微生物学检验与图谱》、《临床微生物学检验图谱(电子图书)》、《临床真菌学图谱》(第二部、第三部)及《实用临床微生物学检验与图谱》(第2版),副主编专著3部,主审1部,参编专著11部。主持科研课题4项,直接参与课题工作26项。
细菌/真菌的形态、染色以及特殊结构是最早和最基本的分 类依据。1683年,荷兰科学家虎克发明了显微镜,并最先观察到 细菌。根据显微镜观察的细菌形态,人们最初将细菌分为球菌、 杆菌和螺旋菌三大类。1884年,丹麦细菌学家汉斯·克里斯蒂安 ·革兰(Hans Christian Gram,1853年-1938年)发明了一种新 的染色方法,并根据细菌染色的着色情况分为革兰阳性菌和革兰 阴性菌两大类。固体培养基的发明和纯培养技术,进一步为细菌 的表型分类研究奠定了基础。
形态学检查是临床微生物检验重要的鉴定手段之一,有助于 对病原微生物的初步鉴定,也是检验技术人员决定选用鉴定试 剂的重要参考依据,更是选择药敏试验组合的重要依据。随着 自动化鉴定仪器的普及和使用,细菌鉴定越来越规范,鉴定准确 性有了很大的提高。近几年,质谱技术以及分子测序技术也悄然 走上了前台,一时间似乎进入到精准医学时代了。但全自动细菌 鉴定仪也不是万能的,那些代谢慢、生化反应弱的细菌很难得以 准确鉴定。即使像质谱、分子测序这样“高大上”的技术,也存 在技术上的缺陷,对近缘菌、罕见菌等也不能准确鉴定。一个实 验室如果过分依赖自动化鉴定仪,不重视基本的形态学特性、染 色特性及鉴别性试验(如触酶、凝固酶、氧化酶等试验),鉴定 错误在所难免。经常发生的错误就是选错鉴定试剂(鉴定卡或试条),其结果有两种情况,一是不能鉴定,二是错误的鉴定结 果。后一种情况很难被发现,较前一种结果更具危害性。
如何避免上述情况的发生,以及提高对少见菌和疑难菌鉴定 的准确性,这就需要我们临床微生物检验技术人员加强专业修 养,提高业务水平,掌握包括形态学等基础的微生物学知识。众 所周知,鉴定细菌的原则之一就是用最少的试验完成鉴定。形态 学检查就是最基本、最简单、最快速、最直观、最经济的常规鉴定方法,也是确认分离菌株的参考方法之一。细菌形态学包括菌落形态学和细胞形态学。对微生物形态的正确描述依赖于方法学、培养基、培养条件及时间、染色试剂、操作技巧等。
一、细菌的菌落特征
细菌培养特性及生长特征是细菌生物学特性之一, 不同种类细菌可有不同培养特性及生长特征。因此,了 解培养特性并观察细菌生长特征对细菌鉴定和鉴别非常 有帮助。
细菌在固体培养基表面生长形成菌落。对菌落的 描述应包括菌落大小(分大、中、小、菌落直径以1mm为界)、形状、高度、边缘、表面状态、密度(透明度)、硬度(用接种环刮取菌落时的感觉)、菌落内部 结构、颜色、光泽以及与培养基表面的黏附程度,还应 包括菌落的溶血性、气味和色素产生情况等特性。观察 细菌的典型形态,应该是将细菌接种在该细菌最适生长 的培养基上、放入该细菌最适生长的环境中(包括温 度、湿度和所需气体等条件)进行孵育,孵育时间应视 细菌的生长速度而定。大部分常见的细菌以培养24h为 宜,有些细菌需要更长时间的孵育才能显现出典型的菌 落特征。有时为了鉴别某一种或某一类细菌,需要观察 细菌在特殊的培养基(包括显色培养基)上或在特定环 境下(气体、温度和光线等)培养的形态特征。
观察菌落特征的目的是为了对细菌进行初步鉴定。 有些特征是某些细菌所特有的,具有属或种的鉴别价 值,如肺炎链球菌在绵羊血琼脂平板上的脐窝样菌落及 黏液型菌落(如图1)、伴放线凝集杆菌菌落特殊的内 部结构、侵蚀艾肯菌的斗笠样菌落和陨石坑样菌落(如图2)、斯氏假单胞菌(及黄色单胞菌和金色单胞菌)的皱纹样菌落(如图3左)、变形杆菌迁徙样菌落、嗜麦芽窄食单胞菌的“猫眼”菌落等(如图3右)。
菌落的颜色及气味也具有鉴别价值。铜绿假单胞菌 的水溶性色素、紫色色杆菌的脂溶性色素、沙雷菌的红 色色素、荧光假单胞菌产生的黄色荧光素、某些厌氧菌 可产生砖红色荧光素等。变形菌科细菌产生类似巧克力蛋糕的气味、铜绿假单胞菌产生类似豆面煎饼的气 味、产吲哚金黄杆菌产生的吲哚气味、嗜血杆菌产 生的鼠穴气味、诺卡菌产生的腐土气味、类香味菌 产生一种令人愉悦的的芳香气味、厌氧菌产生的腐 氨气味等。有些细菌产生色素受到气体因素的影响 (如黏质沙雷菌在厌氧环境下不产色)(如图4),有些细菌产生色素受到光线的影响(某些快速生长分枝杆菌是光产色或暗产色)。其他不常见细菌的菌落形态,见图5~图21。

图1. 肺炎链球菌脐窝样菌落(左) 肺炎链球菌黏液型菌落(右):涂片染色都是革兰阳性球菌

图2. 侵蚀艾肯菌(扩散型菌落)(左)(陨石坑型菌落)(右):侵蚀艾肯菌菌落形态很多,但其主要特征是扩散生长,无论是草帽样、斗笠样、铆钉样菌落都是扩散生长的趋势

图3. 斯氏假单胞菌(左) 嗜麦芽窄食单胞菌(右):斯氏假单胞菌分离株一部分是光滑型菌落,一部分是褶皱样菌落,很干,难刮下,不易涂片检验;嗜麦芽窄食单胞菌有典型的“猫眼”样菌落,但一般在培养48h以后出现
图4. 黏质沙雷菌(左 大气环 境培养产色素)(右 厌氧培 养不产色素)

图5. 龋齿罗氏菌(左) 星型诺卡菌(右):龋齿罗氏菌典型菌落特征多是纽扣样菌落,白色;诺卡菌颜色多种,有黄色、白色等,菌落表面粗糙

图6. 卡他莫拉菌(左) 白色拟诺卡菌(右):卡他莫拉菌菌落肉眼观查为光滑型,但菌落易碎,接种环压菌落易碎,推菌落可移动(不粘琼脂),呈冰球样移动

图7. 耐酪酸冢村菌(左) 海迪茨氏菌(右):均为革兰阳性杆菌,耐酪酸冢村菌粗糙一些,镜下菌体长一些;海迪茨氏菌菌体短一些

图8. 枯草芽胞杆菌(左) 地衣芽胞杆菌(右)

图9. 蜡样芽胞杆菌(左) 梭形芽胞杆菌(右):蜡样芽胞杆菌可以引起食物中毒和结膜穿孔;梭形芽胞杆菌迁徙生长,较变形杆菌动力更强,生长更快,且无变形杆菌的气味是其鉴别点

图10. 龋齿罗氏菌:车辐样菌落(左),轴承样菌落(右)

图11. 痰戈登菌(左) 齿龈二氧化碳嗜纤维菌(右)

图12. 诺卡菌(左) 韦腊链霉菌(右):诺卡菌呈干燥或蜡样,黄白不等,有棘突或气生菌丝

图13. 星座链球菌(左) 枯草芽胞杆菌(右):星座链球菌菌落小,肉眼观测平板形似满天星;枯草芽胞杆菌在MH平板上呈黏液型菌落,形态如宝石样

图14. 艰难梭菌扩散生长(PY琼脂)(左),变形杆菌扩散生长(右)

图15. 紫色色杆菌(左)深红沙雷菌(右):血平板未加亚碲酸盐,因而菌落的颜色是紫色色杆菌自身产生;右图是MH琼脂平板,并非显色培养基,因而菌落的红色也是由深红沙雷菌自身产生

图16. 浅黄金色单胞菌(左) 栖稻黄色单胞菌(右)

图17. 黏质沙雷菌(左)玫瑰库克菌(右):黏质沙雷菌有些菌株产色素,有些不产色素,左图的黏质沙雷菌菌株会产生红色色素,但菌落特征显示为红色和白色两种,无论挑取红色菌落还是白色菌落,培养出来依然是红白相间的菌落特征,这也是黏质沙雷菌异质性产色素的表现;阳性球菌如玫瑰库克菌也会产生色素

图18. 中间普雷沃菌(左) 牙龈卟啉单胞菌(右):厌氧菌5天以上的时间才能产生黑色素,才能鉴别开

图19. 表皮葡萄球菌(左) 洋葱伯克霍尔德菌(右):一些特殊的细菌如表皮葡萄球菌可产生淡紫色的色素;洋葱伯克霍尔德菌群有时也会看到紫色色素,但需要注意的是,我们测得的洋葱伯克霍尔德菌可能并不是一个种,而是一个群,常规鉴定手段不能分辨出来

图20. 颈玫瑰单胞菌(左) 嗜中温甲基杆菌(右):两图都是非发酵菌,产生粉红色色素。黏液型的是玫瑰单胞菌;菌落小一些、生长缓慢的是甲基杆菌,它也产生粉红色色素,甲基杆菌吸收长波紫外线,通过紫外线吸收试验可以进行分辨

图21. 嗜肺军团菌(左) 链霉菌(右):嗜肺军团菌菌落在强光照射下,会产生像教堂彩色玻璃样的颜色;MH平板上菌落产生绿色色素的链霉菌
二、细菌/真菌的菌体形态特征
临床微生物学实验室仍然使用细胞形态学的方法 进行细菌鉴定,革兰染色细胞形态学是细菌分类学的 基础。掌握细胞形态学的标准方法能够为准确鉴定细 菌提供可靠保证。很难想象革兰染色的错误会导致正 确的鉴定结果。对细菌菌体形态特征的观察和描述是 细菌鉴定的第二步骤,其主要目的体现在以下几方 面。(1)可解释培养结果、确定鉴定方向;(2)是鉴别细菌的手段;(3)是鉴定方向及试剂选择的依据;(4)是药敏组合选择的依据。
1. 解释培养结果、确定鉴定方向:无论是液体 培养(如血培养、标本直接增菌培养)或是固体培养(接种培养皿),都应该将培养物进行涂片、染色镜 检确定培养物的性质,既可快速报告,也是为下一 步的鉴定指明方向。例如,血培养报阳后,经革兰染 色,发现阳性分枝状长杆菌,怀疑是诺卡菌,涂片经 弱抗酸染色为阳性,基本能确定为诺卡菌属。在危急 值报告时,若将报告备注为疑似诺卡菌属,对临床 用药来说就非常精确了。诺卡菌生长缓慢,需要培养 数天才能确认,等确认后再报告,黄金六小时已经过 去,将会耽误患者的病情。这就需要跟医务处(科)协商好,口头报告与正式报告可能有一定的差距,以 避免后续不必要的纠纷产生。这需要检验技术人员拥 有扎实的形态学基本功才能胜任。
2. 鉴别细菌/真菌的手段:细菌/真菌菌体形态结 合菌落形态特征可进行初步鉴定。例如,在选择性巧 克力平板(加万古霉素)上生长的草绿色溶血菌落, 是乳杆菌还是肠球菌(VRE)只要涂片镜检就很容易区分。鲍曼不动杆菌与克雷白菌属的菌落形态相似, 镜下区别前者为革兰阴性球杆菌(接近球菌),后者为革兰阴性杆菌;丹毒丝菌在血平板上的菌落形态与草绿色链球菌很相像,但镜下形态差别很大。
3. 鉴定方向及试剂选择的依据:葡萄球菌和链球菌、革兰阳性球菌和革兰阳性杆菌、芽胞杆菌和非芽胞杆菌、革兰阴性球菌和革兰阴性杆菌的鉴定方向完全不同,试剂选择也不同,如果选错试剂结果必然是错误的,有些错误的结果很难被发现,最终导致临床治疗的失败。
4. 区分球菌或杆菌的方法(L型诱导实验):莫 拉菌属中的卡他莫拉菌和其他莫拉菌均为氢化酶阳 性、无动力及不分解糖的细菌,两者唯一的不同是卡 他莫拉菌是球菌,其他莫拉菌是球杆菌或杆菌,常成 双排列似双球菌。实际工作中凭镜下形态很难鉴别二 者。Catlin1975年介绍了一种区别球菌与球杆菌的简 单方法,就是将待检细菌划线接种于血琼脂平板后贴 一片青霉素(10U)药敏纸片,经18~24h孵育。取抑 菌环边缘的菌落涂片染色镜检。在青霉素亚抑菌浓度 的影响下,杆菌/球杆菌可形成长而呈丝状的菌体,而 球菌则仍为球菌,仅是细胞体积增大。借此试验可将 球菌和球杆菌予以鉴别。
5. 区分革兰染色阳性或阴性的方法(氢氧化钾拉丝试验):有些革兰阴性细菌抗酒精脱色,易被染 成革兰阳性,给后续鉴定一个错误的信息,后果很严 重。因此,需要一种方法来解决这个老大难问题,氢 氧化钾拉丝试验可以很好地解决这一难题。该试验原 理是由于革兰阴性细菌的细胞壁较薄,在稀碱溶液中 易于破裂,释放出未断裂的DNA螺旋,在强碱作用下 呈黏液反应,可用接种环搅拌后挑出黏丝来。而革兰 阳性细菌由于细胞壁较厚,在稀碱溶液中不易于破 裂,没有上述变化。用接种环挑出黏丝者为拉丝试 验阳性,仍为混悬液者为阴性。试验时以葡萄球菌为 阴性对照,以大肠埃希菌为阳性对照。
6. 药敏组合选择的依据:CLSI文件规定,每一 种细菌都有一定的抗菌药物组合供选择。要准确进行 药敏组合选择,就必须有准确的细胞形态学结果作支持。如果把球菌和杆菌、革兰阴性和革兰阳性细菌混淆了,最终结果将会出现偏差,报告临床的后果不堪设想。准确的形态学检验结果,可以避免药敏组合选择的错误发生。
三、菌体特殊结构的观察
1. 荚膜:荚膜是某些细菌在细胞壁外包裹的一层 黏液性物质,一般由多糖和多肽组成。荚膜作为细菌 的毒力因子有必要对其染色观察,荚膜肿胀试验可特 异性的鉴定细菌。最常见的是新型隐球菌的墨汁染色 可以看到荚膜,很多细菌也可做荚膜染色。
2. 鞭毛:鞭毛是细菌的运动器官,观察细菌鞭毛对于细菌鉴定有十分重要的意义。依据鞭毛的有无、 位置和数量,细菌分为无鞭毛菌、单端极鞭毛菌、单端双鞭毛菌、单端丛鞭毛菌、周鞭毛菌、侧鞭毛菌 等。临床实验室可用动力试验验证细菌鞭毛的存在,但动力试验无法代替鞭毛染色在细菌鉴定中的地位。单侧有一根鞭毛的细菌是弧菌属;单侧有一根到多根的为假单胞菌属;周身鞭毛的细菌在非发酵菌里有产碱杆菌,在发酵菌里的肠杆菌目里除了克雷伯菌属基本都是周身鞭毛;一侧一根鞭毛的细菌可能为螺旋菌。
3. 芽胞:芽胞是芽胞杆菌休眠期的一种特殊形态。芽胞的形态包括芽胞形状、芽胞位置和胞子囊膨大,芽胞形态分为圆柱形、椭圆形、球形,芽胞位置分为端生、近端生、中生或近中生。根据芽胞的形态学可以对芽胞杆菌属和梭菌属进行初步鉴定。芽胞杆菌的鉴定有专用的试剂,不可与其他细菌的鉴定试剂混用。观察芽胞的方法很多,有染色法和直接观察 法。但芽胞染色并不优于革兰染色,使用相差显微镜 观察芽胞优于芽胞染色和革兰染色。
4. 异染颗粒:异染颗粒其主要成分是多聚偏磷酸 盐,可随菌龄的延长而变大。多聚磷酸盐颗粒对某些染料有特殊反应,产生与所用染料不同的颜色,因而得名异染颗粒。如用甲苯胺蓝、次甲基蓝染色后不呈蓝色而呈紫红色。棒杆菌属和某些芽胞杆菌常含有这种异染颗粒。常见于白喉棒杆菌,异染颗粒位于菌体两端,故又称极体,有助于该菌的鉴定。白喉棒杆菌的亚甲蓝染色一般要求1min,而日常工作中染色1min就不能看到异染颗粒了,做异染颗粒一定不能超过30s。
四、标本直接涂片镜检
2011年世界卫生组织(WHO)对临床微生物实验室提出三项指导性方针:临床微生物实验室尽可能把目标集中在快速诊断方面,显微镜检查对建立快速的初步诊断具有很大价值,实验室人员必须主动与临床结合将实验室数据转化为临床有用的信息。操作最简单、费用最低、用时最短,结果最直观的检验方法就是标本直接涂片显微镜检查。可在第一时间向临床报告镜下所见,医生根据镜检结果可初步做出诊断,并以此进行针对性用药。
1. 标本涂片制作方法:制片很重要,涂片的制备水平及染色的质量,直接影响到镜检的结果。制片基本要求是:涂片的厚薄以镜下见到单层细胞为宜;染色结果以细胞核、浆清晰,胞内吞噬物清楚可见,革兰染色阴、阳性分明为佳。制片步骤为:标本处理、制片、固定、染色。但 较黏稠的标本制片时不易涂抹均匀,制出的片厚薄不均,质量不佳。 对此笔者推荐一种压片方法,可以取一点黏稠标本在玻片上,用另一张玻片竖着盖上,将标本压扁,再平拉开盖在上面的玻片,即可完成压片,这样制出来的涂片中标本分布均匀,又不破坏细胞的结构。制片的质量控制有:(1)制片厚薄适中;(2)镜下单层细胞;(3)胞浆清晰;(4)胞内、胞外细菌轮廓清晰,病原菌阴、阳性分明;(5)细菌荚膜清晰可见。肉眼判断染色后的标本着色均匀,且纸上的 字透过玻片清晰可见就是合适厚度的制片。以下是部分典型的标本直 接涂片中的病原菌形态特征,见图22~图36。

图22. 痰涂片革兰染色:卡他莫拉菌,卡他莫拉菌与奈瑟菌的鉴别要点是奈瑟菌多成双(短轴相对)或成簇排列(不被白细胞吞噬),卡他莫拉菌成双排列(多见被白细胞吞噬);与不动杆菌的鉴别要点是不动杆菌多呈单个或链状排列(偶尔会看到杆状菌体),有些菌株有明显的荚膜,不易被细胞吞噬,易被染成革兰阳性

图23. 脑脊液涂片(化脓性脑膜炎标本)革兰染色,脑膜炎奈瑟菌

图24. 尿道分泌物涂片革兰染色(淋病奈瑟菌),感染急性期细胞吞噬明显

图25. 尿道分泌物涂片革兰染色(淋病奈瑟菌),感染慢性期细胞吞噬不明显,加上细胞不完整,提示临床可能是疗程不足或耐药菌株出现

图26. 阴道分泌物涂片革兰染色,看到这样的革兰阴阳性不明确的小杆菌布满细胞上,考虑为线索细胞,小杆菌为阴道加德纳菌

图27. 痰涂片革兰染色,细菌革兰阳性,有荚膜,形似隐球菌(已确认),推荐进行血清学验证

图28. 脓汁涂片革兰染色,有细胞趋化包裹现象,细菌呈葡萄串状排列,为金黄色葡萄球菌

图29. 痰涂片革兰染色,被细胞包裹的是黏液型铜绿假单胞菌

图30. 痰涂片革兰染色,腊肠样排列的是黏液型铜绿假单胞菌,砖红色的黏液成分是藻酸盐的颜色,有别于荚膜的颜色(革兰染色荚膜不着色)

图31. ICU病人的痰涂片革兰染色,黏液型鲍曼不动杆菌的荚膜透亮明显,有别于黏液型铜绿假单胞菌的藻酸盐黏液的颜色

图32. 痰涂片革兰染色,是黏液型的肺炎克雷伯菌,看似是圆形菌体,实际是方形(有别于不动杆菌),荚膜橘红色(与黏液型铜绿假单胞菌的藻酸盐黏液颜色相近)

图33. 这是两组图片,左侧两张革兰染色图片中看不出什么细菌,但在细胞里好像有一些着色的点状物,怀疑是否为分枝杆菌,原片复染抗酸染色,找回相同视野(右侧两张图片),看到抗酸阳性的分枝杆菌,证实之前革兰染色镜检的判断是正确的,经鉴定为结核分枝杆菌

图34. 痰涂片革兰染色,这是一组图片,上图为革兰染色,镜下所见为不着色的“鬼影细胞”;下图为抗酸染色,镜下发现大量抗酸阳性的分枝杆菌,经鉴定为结核分枝杆菌

图35. 痰涂片革兰染色从菌丝的形态判 断,曲霉菌的可能性最大(已确认),此图中的菌丝都是被白细胞包裹的,且白细胞几乎没有完整的,都是核固缩,核碎裂的形状,是严重核退行性变的表象,这是曲霉产生的细胞毒素对细胞毒性作用结果导致的,这一点很重要,在没检出病原体的情况下是一种复检的提示



图36. 痰标本涂片及培养:(图1)为革兰染色,菌体大小不一,有很厚的荚膜,需排查隐球菌可能;(图2)是墨汁染色,看着也非常像隐球菌;但是仔细观察,发现革兰染色阴性的偏多(复检后也是如此),在这种情况下,不能马上报隐球菌阳性(可能会报错),如果是隐球菌感染晚报一天应该对患者影响不大,如果报错了可能误导医生用抗真菌药物,后果严重。如果有隐球菌荚膜抗原试剂,可以做鉴别诊断,如果没有或是检测出阴性结果,建议等培养结果出来再进行判断。此病例在第二天,看细菌培养的平板,平板上长出了圆形凸起、灰白色光亮大菌落,有拉丝现象(图3),涂片染色镜检排除了真菌,鉴定结果是高毒力的黏液型肺炎克雷伯菌。后询问临床得知,患者在留取样本前用了一天的比阿培南,后经体外实验验证比阿培南可诱导革兰阴性杆菌发生球形变现象
五、细菌形态学是微生物实验室报告审核的重要依据
对检验结果的审核是临床微生物实验室检验流程的最后一道工序,应该由技术全面的技术人员进行把关。审核报告应该从检验审请单、感染部位选择、标本的采集运送与处理、标本直接涂片、镜检结果的描述、标本的接种和孵育、菌落形态观察和描述、菌落涂片镜检结果描述、附加试验的选择及结果判断、免疫学试验结果分析、生化试剂的选择与结果观察记录、专家系统提示内容解读、抗菌药物组合的选择和结果分析、以及室内质控结果等全过程进行综合分析,必要时还应征求临床医生对疾病诊断的意见,了解患者病情及用药的相关信息。最终鉴定结果必须与形态学结果相符,如果出现不符合结果,尤其在药敏试验结果与鉴定结果相矛盾时(即无法解释的耐药表型),首先应审核鉴定结果与形态学结果是否相符,如果结果不相符,应该审核整个检验过程,找到问题所在,并重新进入鉴定程序。
六、小结
综上所述,微生物形态学的检查,对鉴定病原菌有“导航”的作用,正确的形态学检验结果是准确鉴定细菌的坚实基础。这就要求每一位从事临床微生物检验的技术人员必须掌握一定的形态学知识,并在实际工作中不断学习、总结提高,早日成为一名优秀的临床微生物检验工作者,为临床治疗感染性疾病提供优质服务。多干、多看,实践出真知,多看文献图片有助于快速掌握形态学知识。形态学是微生物检验技术人员的基本功课,必须掌握。形态学检验技术在临床微生物鉴定中体现出的是“黄金”价值。
参考文献
陈东科. 加强形态学检查提高细菌鉴定的准确性[J]. 实验与检验医学, 2012, 30(5): 419-421.
中国医师协会检验医师分会感染性疾病检验医学专家委员会.临床微生物检验诊断报告模式专家共识[J]. 中华医学杂志, 2016, 96(12):937-939.
魏莲花, 邹凤梅, 刘刚, 等. 临床微生物形态学及特殊耐药性检测室间质量评价体系的建立及应用[J]. 临床检验杂志, 2017, 35(7): 538-541.
陈东科, 孙长贵. 实用临床微生物学检验与图谱[M]. 第1版. 北京:人民卫生出版社, 2011.
陈东科. 微生物图片拍摄技术的应用探讨.临床检验杂志, 2017, 35(10): 729-735
陈东科. 微生物形态学检验在感染性疾病诊断中的地位和价值.临床检验杂志(电子版), 2012, 1(2): 65-75.
陈东科, 孙长贵. 临床微生物学检验图谱. 北京: 人民卫生电子音像出版社, 2016

